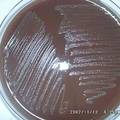

基本信息
- 项目名称:
- 流感嗜血杆菌血清型与耐药性关系及其机制研究
- 来源:
- 第十二届“挑战杯”省赛作品
- 小类:
- 生命科学
- 大类:
- 自然科学类学术论文
- 简介:
- 本课题组对临床分离的399株流感嗜血杆菌临床株进行了血清分型、耐药表型和耐药机制研究,同时进行了荚膜基因检测,以期阐明流感嗜血杆菌的主要耐药模式、主要血清分型及主要耐药机制别,为临床流感嗜血杆菌感染的经验治疗和疫苗的预防接种取向提供有价值的参考依据,也为该菌耐药株的鉴定和荚膜分型提供快速检测方法。
- 详细介绍:
- 流感嗜血杆菌(Haemophilus influenzae,Hi)是人类社区获得性肺炎的最常见病原菌之一,还常常引起儿童中耳炎、上呼吸道感染等疾病。Hi根据细胞壁外荚膜多糖的有无,分为有荚膜的可分型和无荚膜的不可分型两类,前者可分为a,b,c,d,e,f六个血清型,常引起侵袭性疾病。但近年研究发现,随着Hib菌苗的广泛接种,有荚膜菌株已少见,不可分型菌株已成为主流菌型。不同型别的Hi引起的常见疾病种类不同。因此Hi所致疾病与血清分型有密切关系。对于Hi治疗,氨苄西林是历史沿袭的首选药物。世界各Hi 菌株对β-内酰胺类抗生素的耐药率正以较快的速度上升,而且不同地区差异很大。本课题组前期研究发现Hi不定型株的耐药率高于有荚膜菌株的趋向,进行Hi血清分型和细菌耐药机制研究对于该菌临床流行病学研究和感染的经验治疗均有重要意义。因此,本课题组对临床分离的399株流感嗜血杆菌临床株进行了血清分型、耐药表型和耐药机制研究,同时进行了荚膜基因检测,以期阐明流感嗜血杆菌的主要耐药模式、主要血清分型及主要耐药机制别,为临床流感嗜血杆菌感染的经验治疗和疫苗的预防接种取向提供有价值的参考依据,也为该菌耐药株的鉴定和荚膜分型提供快速检测方法。
作品专业信息
撰写目的和基本思路
- 目的:对临床分离的399株Hi临床株进行血清分型、耐药表型和耐药机制研究,同时进行荚膜基因检测,以期阐明流感嗜血杆菌的主要耐药模式、主要血清分型及主要耐药机制别,为临床流感嗜血杆菌感染的经验治疗和疫苗的预防接种取向提供有价值的参考依据。 思路:E-test法进行药敏试验,玻片凝集法进行血清分型,Cefinase纸片测定β-内酰胺酶,PCR扩增耐药基因、荚膜基因,扩增产物经凝胶成像系统分析。
科学性、先进性及独特之处
- 本项目紧密结合临床,通过对Hi血清型和荚膜基因分型检测的比对研究及菌株耐药表型和耐药机制研究,阐明本地区Hi以不定型株为主,菌株耐氨苄西林机制主要是产生TEM基因,针对TEM基因的PCR扩增有助于快速确定Hi对氨苄西林的耐药性。研究中还建立了应用荚膜基因检测对菌株进行分型的方法,具有良好的科学价值和实用价值。在国内现有文献中,未见关于流感嗜血杆菌耐药性、菌株分型和耐药机制关系的研究报道。
应用价值和现实意义
- 本课题研究结果发现:儿童分离的Hi以不定型株为主,且不定型株比例逐年增高,菌株对氨苄西林的耐药率逐年增加,其耐药机制主要是产β内酰胺酶,且均为TEM产酶机制,3岁以上个体来源的菌株产酶率高于3岁以下组;不定型株对氨苄西林的耐药性高于可分型株;bexA-PCR可快速区分菌株型别。上述结果对Hi感染的经验治疗、耐药性和菌型的快速判断以及b型菌苗的接种价值评价具有科学价值和实用价值。
学术论文摘要
- Hi是人类社区获得性肺炎最常见病原菌之一,根据细菌细胞壁外荚膜多糖的有无,分为可分型和不可分型两类,前者分为a、b、c、d、e、f六个血清型。近年来,世界各Hi菌株对氨苄西林等β-内酰胺类抗生素及复方新诺明的耐药率正以较快的速度上升,但不同地区菌型分布和耐药性特点差异巨大。本研究应用Etest法和K-B法完成菌株的药敏试验,用玻片凝集法完成菌株血清分型,用头孢硝噻吩法检测β-内酰胺酶,用PCR技术检测菌株的耐药相关基因TEM和 ROB,并应用多重PCR对Hi进行荚膜基因分型,结果发现:儿童分离的流感嗜血杆菌以不可分型株为主,占61.9%-94.73%,且不可分型株比例有逐年增高趋势,菌株对氨苄西林的耐药率逐年增加,耐氨苄西林的耐药机制主要是产生β内酰胺酶,且均为TEM产酶机制,3岁以上个体来源的菌株产酶率高于3岁以下组;不可分型菌株对氨苄西林的耐药性高于可分型株;bexA-PCR可快速区分菌株型别。本研究可为临床流感嗜血杆菌感染的经验治疗和疫苗的预防接种取向提供有价值的参考,也为该菌耐药株的鉴定和荚膜分型提供快速检测方法,具有科学价值和实用价值。
获奖情况
- 《流感嗜血杆菌耐药模式监测及耐药机制研究》于2011年3月发表在中华检验医学杂志第34卷第3期。 《流感嗜血杆菌血清型与耐药性关系及其机制研究》获2011年杭州师范大学第十二届“挑战杯”大学生课外学术科技作品竞赛一等奖。 《流感嗜血杆菌血清型与耐药性关系及其机制研究》获2010年浙江省新苗人才计划立项。 《流感嗜血杆菌耐药机制研究》获2010年杭州师范大学第十一届“挑战杯”大学生课外学术科技作品竞赛三等奖。
鉴定结果
- 情况属实。
参考文献
- 现有技术: (1)V因子、X因子和V+X因子试验鉴定流感嗜血杆菌。 (2)Kirby-Bauer法检测流感嗜血杆菌对氨苄西林的敏感性, E-test法检测氨苄西林的最低抑菌浓度。 (3)Cefinase纸片按说明书测定菌株的β-内酰胺酶。 (4)玻片凝集法进行血清分型。 (5)多重聚合酶链反应扩增DNA,琼脂糖凝胶电泳加凝胶成像系统分析PCR扩增产物。 (6)SPSS13.0版分析软件对实验数据进行χ2检测。 技术文献检索目录: 1.钱夏婧,景伟兴,冯旭敏等.流感嗜血杆菌耐药模式监测及耐药机制研究[J].中华检验医学杂志,2011,34(3)1-3. 2.钱夏婧,华春珍.不定型流感嗜血杆菌的研究进展[J].中华预防医学杂志,2010,11(7)740-745. 3.程薇,钱利强,华春珍等.儿童呼吸道标本分离的流感嗜血杆菌耐药模式研究[J].检验医学,2010,25(3)192-195. 4.钱利强,程薇,华春珍等. 流感嗜血杆菌对氨苄西林耐药性及耐药机制研究进展[J].中国抗生素杂志,2009,34(2)69-73. 5.裘益辉,张艳,华春珍,等.杭州市上呼吸道感染患儿分离的流感嗜血杆菌分离株的血清分型及其对氨苄西林的耐药性分析[J].中国当代儿科杂志,2009,11(3)217-220. 6.张艳,裘益辉,华春珍等. 流感嗜血杆菌分型的研究进展[J].中国预防医学杂志,2009,10(5)430-433.
同类课题研究水平概述
- Hi对氨苄西林耐药率逐年增高给治疗带来很大挑战。国内、外现已运用血清学和分子生物学等诸多方法检测Hi及其分型,并对Hi的耐药率实施监测,为临床循证诊断和合理指导应用抗生素提供了有力依据。PCR指纹图是利用引物与模板的复性位点的特异选择扩增多态性的DNA,用一条引物在较低温度下与模板复性,在模板适当位置相对延伸,产生不同长度的扩增片段,经电泳后即可见扩增片段形成的DNA指纹图,又称DNA多态性的随机扩增 (RAPD),可用于流行病学调查,尤其在检测变异株形成及耐药性变化等方面,并能检测血清学分型株之间的基因多态性。Peerbooms等通过RAPD方法检测 259名日托儿童鼻咽部Hi携带株发现,39%的儿童(37/95)在2周后第2次检测显示携带Hi,大部分携带的Hi是与2周前第1次检测到基因型的不同,且其中有 40%的儿童携带株与第1次检测中其他阳性儿童Hi基因型相同,提示儿童鼻咽部携带的Hi是短暂和不断变化的,不同基因型Hi可在儿童间快速传播。Tenover等使用 PCR法检测脑脊液中Hi的同时,用基因探针检测耐氨苄西林的基因,可进一步区分其中的氨苄西林耐药菌株,为临床治疗提供指导。Hassan-King等则采用复合PCR法,采用两对引物同时扩增,在同一反应体系中同时检测肺炎患儿血培养标本中Hi和肺炎链球菌,并与血培养法结果比较,提示复合PCR法是检测血标本中这两种病原菌的敏感方法,是一种试图提高检测率的成功尝试。近年来还有学者通过巢式聚合酶链反应( nested-PCR)检测Hib。姜敏等运用nested-PCR与玻片凝集法检测Hib及氨苄西林耐药株。在74株通过 E-test证实对氨苄西林耐药的健康儿童鼻咽部携带的Hi中,用 nested- PCR发现2株有b型特异性荚膜基因阳性,与玻片凝集法结果一致,判断为Hib。提示nested-PCR b型荚膜检测法可作为玻片凝集法的一个重要补充。国外对耐氨苄西林Hi产β-内酰胺酶的分子机制研究,主要是在大量培养细菌的基础上,通过CsCl密度梯度超离心等方法获取较大量质粒DNA,进行限制性内切酶酶切分析、琼脂糖凝胶电泳、质粒转化试验等,大致分析质粒DNA的大小、结构,验证质粒介导的耐氨苄西林表型等,获得质粒介导的产酶及其与耐氨苄西林药物的关系等的可靠证据。